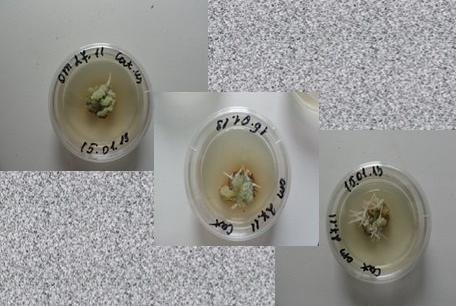

Kazan University researchers developed new unique method of microcloning Сatharanthus roseus

Department of Biotechnologies at the Institute of Fundamental Medicine and Biology headed by the Doctor of Science in Biology, Professor, corresponding member of the Academy of Natural Sciences, Tatiyana Bagaeva was opened on September, 2011. Currently the Department sums up the first results.
In particular, KFU researchers started to microclone Сatharanthus roseus.
This is due to the fact that many of the commercially important compounds used in the pharmaceutics, food and perfume industry, are extracted from cultivated tissues or wild plants. In this regard, there is an active search for new alternative sources of biologically active substances of plant origin. One of these plants is Catharanthus.
We should add that the method of microcloning is used for accelerated reproduction and production of biomass of plant origin, which is difficult or impossible to clone, as well as for rare species of plants, cultivation of which is not possible in our climate.